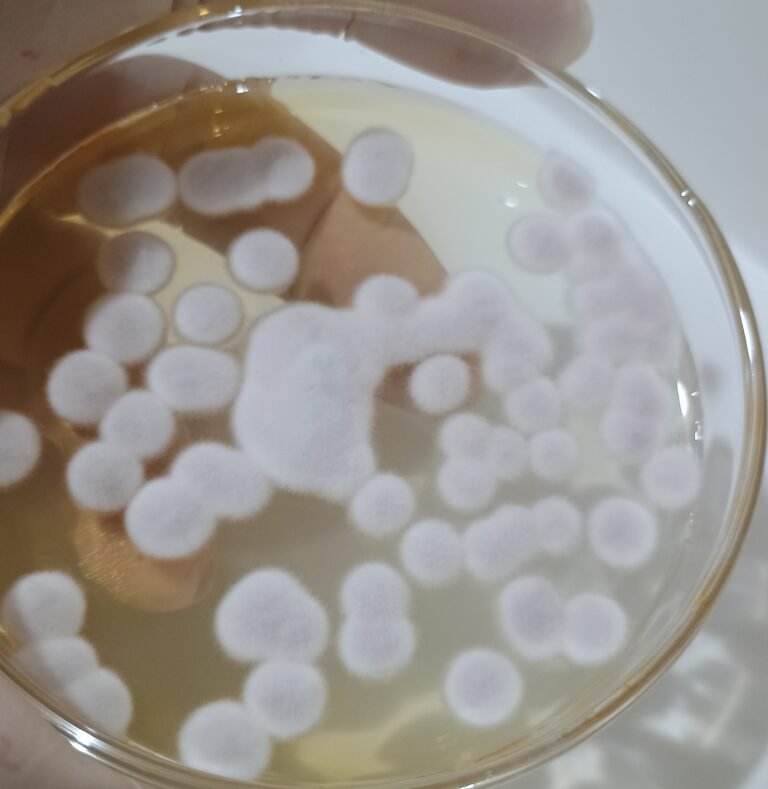

Método Bio OnFarm 2.0
A mentoria prática que ensina o agricultor a produzir seus próprios bioinsumos de forma segura, eficiente e com baixo custo.
Para quem é a Mentoria Método Bio OnFarm 2.0?
✔ Agricultores que querem produzir seus próprios biológicos com segurança.
✔ Técnicos e agrônomos que desejam atuar com mais confiança no on-farm.
✔ Produtores que buscam reduzir custos sem comprometer a eficiência no campo.
✔ Quem quer dominar processos livres de contaminação e com alta qualidade.
✔ Quem deseja autonomia e resultados reais na propriedade.
O que você vai aprender na Mentoria
✔ Como montar um sistema de multiplicação seguro, eficiente e com baixo risco de contaminação.
✔ Como padronizar processos para garantir repetibilidade, qualidade e estabilidade dos seus biológicos.
✔ Como escolher os microrganismos certos para cada necessidade da propriedade (fungos, bactérias e leveduras).
✔ Como preparar inóculo, fazer pré-cultivo e cultivos principais do jeito correto.
✔ Como controlar pH, temperatura, aeração, oxigênio dissolvido e entender o impacto dessas variáveis no crescimento microbiano.
✔ Como interpretar laudos, identificar contaminações e tomar decisões seguras no dia a dia.
✔ Como montar a estrutura mínima de laboratório on-farm, desde materiais básicos até itens que elevam o nível de segurança.
✔ Como aplicar os biológicos no campo para ter resultado real, com economia, autonomia e eficiência.
O que você recebe ao entrar na mentoria
✔ 6 encontros ao vivo pelo Google meet para tirar dúvidas, ajustar processos e acompanhar seu avanço real no on-farm.
✔ Aulas gravadas, direto ao ponto, com explicações práticas do que realmente funciona na produção de biológicos.
✔ Materiais complementares: planilhas, protocolos, listas de verificação e modelos para usar no dia a dia.
✔ Rota de Implementação para você saber exatamente por onde começar e o que fazer a cada etapa.
✔ Grupo exclusivo no WhatsApp, com suporte contínuo, troca com outros produtores e acompanhamento próximo.
✔ Apoio técnico direto, baseado nas suas condições reais de propriedade.
✔ Acesso por 12 meses, para rever tudo quando quiser e acompanhar as atualizações.
Quem é a Mentora

Sou Ligiane Aparecida Florentino, Engenheira Agrônoma, Mestre e Doutora em Microbiologia Agrícola.
Há mais de 20 anos trabalho unindo ciência e prática no campo, ajudando agricultores a produzirem seus próprios biológicos com segurança e eficiência.
✓ Co-fundadora da SINBIOMA ON-FARM.
✓ Especialista em controle de qualidade e protocolos de produção.
✓ Já treinei dezenas de agricultores e técnicos em bioinsumos on-farm.
Por que a Mentoria Método Bio OnFarm 2.0 é Diferente?
✓ Baseado em ciência e validação no campo.
✓ Foco total em segurança microbiológica.
✓ Fácil de aplicar, mesmo para iniciantes.
✓ Acompanhamento real e suporte individual.
✓ Adaptado ao contexto da sua propriedade.
✓ Ética e responsabilidade conforme a Lei de Bioinsumos.

O que os alunos dizem sobre o Método Bio OnFarm 2.0


Contato para suporte e dúvidas sobre a mentoria:
WhatsApp: (35) 9 9236-0344
E-mail: sinbiomaagro@gmail.com; ligianeflorentino@gmail.com
(Atendimento de segunda a sexta, das 8h às 18h)